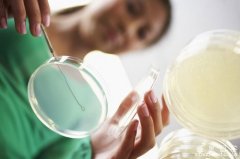

[日本留学快讯] 日本语言学校DIY申请流程全攻略 日期:2015-01-22 08:08:11 点击:1118 好评:0
[日本留学快讯] 日本语言学校DIY申请流程全攻略 日期:2015-01-22 08:08:11 点击:1118 好评:0
日本语言学校DIY申请流程全攻略,想要去日本留学是否必须要先读语言学校呢?对于想要去读日本语言学校的同学来说如何DIY申请日本语言学校呢?...
 [日本留学快讯] 日元汇率大跌,论赴日留学的各种优势! 日期:2015-01-21 16:37:43 点击:692 好评:0
[日本留学快讯] 日元汇率大跌,论赴日留学的各种优势! 日期:2015-01-21 16:37:43 点击:692 好评:0
日元汇率的狂跌已经达到了无法收拾的地步,当一个留学热门国家的汇率跌成狗的时候,那么它的留学优势就显现出来了……今天鑫泉留学合肥分公司欧亚文案刘老师给大家分析去日本留学的优势!...
 [日本留学快讯] 留学日本:3类学校学费全攻略|超全 日期:2015-01-21 16:11:27 点击:424 好评:0
[日本留学快讯] 留学日本:3类学校学费全攻略|超全 日期:2015-01-21 16:11:27 点击:424 好评:0
留学日本:3类学校学费全攻略,本文详细介绍了去日本留学,3类学校学费全攻略,有想去日本留学的小伙伴可以关注一下去日本留学的学费问题哦。...
 [日本留学快讯] 日本大学学费最新官方数据! 日期:2015-01-21 13:59:26 点击:731 好评:0
[日本留学快讯] 日本大学学费最新官方数据! 日期:2015-01-21 13:59:26 点击:731 好评:0
日本大学学费最新官方数据!尽管说日元贬值,日本留学费用相对于欧美国家而言低廉很多,但是日本留学费用是一笔很大的开支却是个不争的事实。今天,留学专家为大家介绍,日本大学学费最新官方数据。...
 [日本留学快讯] 日本国立、公立和私立大学的区别! 日期:2015-01-18 15:15:03 点击:645 好评:0
[日本留学快讯] 日本国立、公立和私立大学的区别! 日期:2015-01-18 15:15:03 点击:645 好评:0
日本国立、公立和私立大学的区别!日本留学,在选择大学或大学院是会涉及到大学的区别,会分为国立大学,公立大学,和私立大学,只有了解这三者的区别后,我们才能更好地根据自己日本留学的目的来日本留学选择大学。...
 [日本留学快讯] 手把手教你选择日本名校! 日期:2015-01-18 10:00:06 点击:476 好评:0
[日本留学快讯] 手把手教你选择日本名校! 日期:2015-01-18 10:00:06 点击:476 好评:0
手把手教你选择日本名校!其实选择大学是因人而异,也许你在国内搜索到的情报和真实的情况是有差别的。那么这一期就让我们来扒一扒如何选择自己想考的大学。...
[留学快讯] 适合读研的六大类专业 日期:2015-01-15 17:08:08 点击:726 好评:0
[留学快讯] 适合读研的六大类专业 日期:2015-01-15 17:08:08 点击:726 好评:0
适合读研的六大类专业,来看看有没有你在读的专业呢?对于有意投向科研领域的考生来说,在高考报考时就应该找好自己的方向。那么就需要了解一下哪些专业适合读研,下面就是小编盘点的七大类专业,来看一看有没有你感兴趣的!...
 [留学快讯] 读小语种到底适不适合出国留学呢? 日期:2015-01-15 16:41:44 点击:1385 好评:0
[留学快讯] 读小语种到底适不适合出国留学呢? 日期:2015-01-15 16:41:44 点击:1385 好评:0
读小语种到底适不适合出国留学呢?下面小编就从几个方面来给大家谈谈小语种出国留学的优势,希望能够给大家提供一些参考。...
 [日本行前指南] 揭破中日谣言:中国人真的在日本生活不敢说中文? 日期:2015-01-15 14:55:54 点击:765 好评:0
[日本行前指南] 揭破中日谣言:中国人真的在日本生活不敢说中文? 日期:2015-01-15 14:55:54 点击:765 好评:0
揭破中日谣言:中国人真的在日本生活不敢说中文?基于历史原因,中日两国关系沉浮不定。很多中国人真的在日本生活很“苦逼”?今天我们来揭开中国人在日本生活的真相!...
 [日本行前指南] 如何才能尽早适应日本留学生活? 日期:2015-01-14 19:29:25 点击:1007 好评:0
[日本行前指南] 如何才能尽早适应日本留学生活? 日期:2015-01-14 19:29:25 点击:1007 好评:0
如何才能尽早适应日本留学生活?初到日本,由于语言和教育文化不同,大家可能在一些方面不适应,如课听不太懂,课外活动也不知道该如何参加,也有可能生活上出现一些问题,跟着小编一起来看一些能帮助大家尽早适应日本留学生活的小建议吧~...
日本官房长官加藤胜信在9月27日的记者会上表示,政府将从10月...
如何去日本读修士?日本的院生考试是什么?...
日本留学选择哪个城市好?首选东京,原因是东京教育资源发达...
奥运会期间,这几个专业的毕业生备受关注,盘点和奥运一起走...
日本物价贵?谁说的!看看在日本独居生活一个月要花多少钱?...
日本“编入制”和国内的“专升本”有什么区别?短期大学、专...